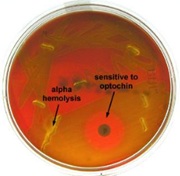
<p>What type of hemolysis means the <strong>partial destruction</strong> of RBC’s (red blood cells) and appears translucent? (example: <em>Streptococcus pneumoniae</em>)</p>
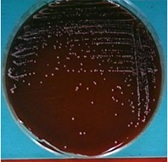
<p>What type of hemolysis means <strong>no destruction</strong> of RBC’s (red blood cells)? (example: <em>Staphylococcus epidermidis</em>)</p>
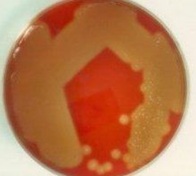
<p>What would be the next step in Identification of the bacterium growing on this plate?</p>
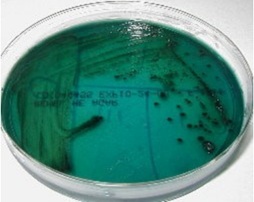
<p>What is the Gram reaction and microscopic morphology of an organism growing on this HE&nbsp;plate?</p>
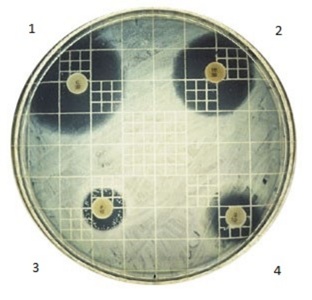
<p>Which disinfectant is the most effective on this plate? Name quadrant</p>
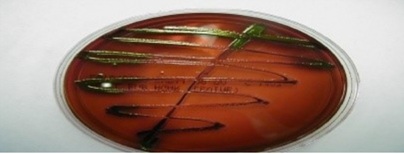
<p>An organism growing on this urine plate is:</p>
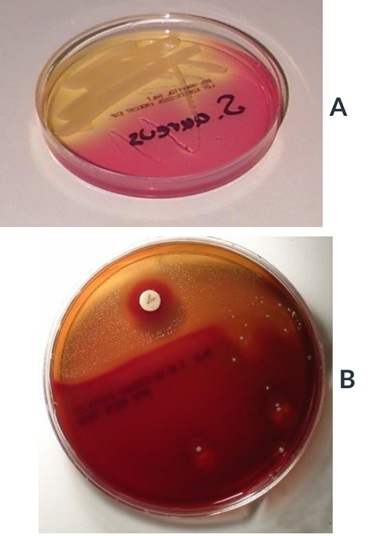
<p>Which of these plates will test positive for Catalase test?</p>

1/40
practice questions
Name | Mastery | Learn | Test | Matching | Spaced | Call with Kai |
|---|
No analytics yet
Send a link to your students to track their progress

Based on the growth pattern within the tube, what type of anaerobic tolerance is this microorganism?
A facultative anaerobe (example: E. coli)

Based on the growth pattern within the tube, what type of anaerobic tolerance is this microorganism?
A microaerophile (example: Microccous luteus)

Based on the growth pattern within the tube, what type of anaerobic tolerance is this microorganism?
An anaerobe (example: Clostridium butyricum)

In regards to the Anaerobic jar, what happens to the strip of methylene blue when oxygen is reduced within the jar?
The strip of methylene blue becomes colorless

What type of hemolysis means the complete destruction of RBC’s (red blood cells) and appears transparent? (example: Streptococcus pyogenes)
β Beta-hemolysis
What type of hemolysis means the partial destruction of RBC’s (red blood cells) and appears translucent? (example: Streptococcus pneumoniae)
α Alpha-hemolysis
What type of hemolysis means no destruction of RBC’s (red blood cells)? (example: Staphylococcus epidermidis)
γ Gamma-hemolysis

This microorganism appears green on EMB plates and pink/orange on HE plates making it a lactose fermenter, which microorganism is it?
E. coli

This microorganism appears pink on EMB plates and pink/orange on HE plates making it a lactose fermenter, which organism is it?
Enterobacter

There are 2 microorganisms that show no color on EMB plates making them lactose non-fermenters. They also form black precipitate on HE plates due to H2S production, which 2 microorganisms are these?
Proteus and Salmonella
What does H2S stand for?
Hydrogen sulfide

This microorganism has no color on EMB plates making it a lactose non-fermenter, but it does appear blue-green on HE plates. Which microorganism is it?
Shigella
What is the primary selective and differential medium (plate) used to distinguish between Staphylococcus aureus and Staphylococcus epidermidis?
Mannitol Salt Agar (MSA) plate

This microorganism appears as yellow on MSA plates due to fermentation of mannitol and causes beta hemolysis on blood agar plates, which microorganism is it?
Staphylococcus aureus

This organism appears as pink on MSA plates because it does not ferment mannitol and causes gamma hemolysis on blood agar plates, which microorganism is it?
Staphylococcus epidermidis
What percentage of sodium chloride (NaCl) is on MSA plates?
7.5% NaCl
What is the catalase test used to differentiate?
It is primarily used to differentiate Staphylococcus (positive, bubbles) from Streptococcus (negative, no bubbles)

Which microorganism causes complete beta hemolysis on blood agar plates and is sensitive to bacitracin (A disk)?
Streptococcus pyogenes

Which microorganism causes partial alpha hemolysis on blood agar plates with a greenish color and is sensitive to Optichin (P disc)?
Streptococcus pneumoniae
What diseases are causes by Staphylococcus aureus?
Impetigo, cellulitis, abscess, boils, furuncle, food poisoning, Toxic Shock Syndrome, septicemia
Which diseases are caused by the Streptococcus species?
Sepsis, scarlet fever, Rheumatic Fever, Necrotizing Fasciitis, Toxic Shock Syndrome, septicemia, nephritis
The indirect ELISA test detects ______ in a patient's blood.
antibodies
Which test is done to confirm a positive ELISA test?
Western Blot test
What is the most common method to collect urine specimen?
Clean catch method
Which of the following methods is used to collect sterile urine specimen?
Catheterization
How do you distinguish between Streptococcus pyogenes and Streptococcus pneumonia?
Streak for isolation and add Bacitracin (A) and Optochin (P) disks
What would be the next step in Identification of the bacterium growing on this plate?
Catalase test
Selective and differential agars used in clinical setting to:
Separate possible pathogen from normal flora
Which media are used for identification of bacteria causing gastrointestinal symptoms?
EMB and HE
Which bacteria are identified by EMB plate?
E.coli and Enterobacter
What is the Gram reaction and microscopic morphology of an organism growing on this HE plate?
Gram (-) bacillus
Which disinfectant is the most effective on this plate? Name quadrant
1.
An organism growing on this urine plate is:
Gram (-) bacterium
Which of these plates will test positive for Catalase test?
A.
Which of the types of media are used to diagnose UTI?
EMB, Blood agar, SAB
Mannitol salt agar is selective for which bacterial genus?
Staphylococcus
What is an indication of a positive Catalase test?
Bubbles
Manitol Salt agar is classified as:
Selective and Differential medium
A patient has a suspicious skin infection and a culture is taken. Which media would be appropriate to select for staphylococci?
Mannitol salt agar
Enterotube is used to distinguish between:
Proteus and Salmonella
The more sensitive bacteria to the drug, the bigger a zone of inhibition will be, True or False?
True